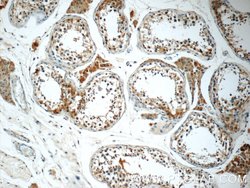
ALLC Rabbit anti-Human, Mouse, Rat, Polyclonal, Proteintech:Antibodies:Primary
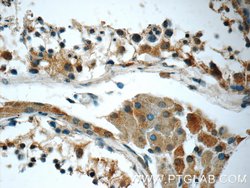
ALLC Rabbit anti-Human, Mouse, Rat, Polyclonal, Proteintech:Antibodies:Primary

missing translation for 'onlineSavingsMsg'
Learn More
Learn More
ALLC Rabbit anti-Human, Mouse, Rat, Polyclonal, Proteintech
Rabbit Polyclonal Antibody
121.38€ - 325.38€
Specifica
| Antigene | ALLC |
|---|---|
| Concentrazione | 0.19 mg/mL |
| Applicazioni | Immunohistochemistry (Paraffin), Immunofluorescence, Immunocytochemistry, Western Blot |
| Classificazione | Polyclonal |
| Coniugato | Unconjugated |
Descrizione
Allantoicase (EC 3.5.3.4) participates in the uric acid degradation pathway. Its enzymatic activity, like that of urate oxidase, was lost during vertebrate evolution.Specifica
| ALLC | |
| Immunohistochemistry (Paraffin), Immunofluorescence, Immunocytochemistry, Western Blot | |
| Unconjugated | |
| Rabbit | |
| Human, Mouse, Rat | |
| Q6AYP0, Q8N6M5, Q9JHX6 | |
| 246758, 55821, 94041 | |
| ALLC Fusion Protein Ag4288 | |
| Primary | |
| -20°C | |
| ALLC |
| 0.19 mg/mL | |
| Polyclonal | |
| Liquid | |
| RUO | |
| PBS with 50% glycerol and 0.02% sodium azide; pH 7.3 | |
| ALC, Allantoate amidinohydrolase, allantoicase, ALLC, Probable allantoicase | |
| ALLC | |
| IgG | |
| Antigen Affinity Chromatography | |
| Antibody |
Individuate un'opportunità di miglioramento?Condividi una correzione di contenuto
Correzione del contenuto del prodotto
Fornite il vostro feedback sul contenuto del prodotto compilando il modulo sottostante.
Titolo del prodotto